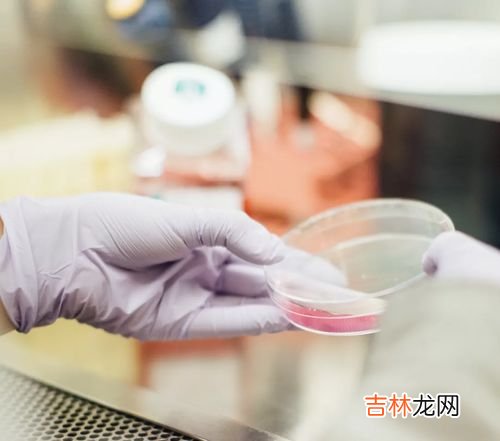

但是无论怎么说,这些水果多多少少都含有糖分,所以都要以少吃为主、要控制摄入的量 , 吃多了难免会影响血糖 。如果添加水果后出现血糖增高,这时候应该适当减少饭量,一加一减就能够保证摄入的热量维持在一个合理的范围,这样才不至于会导致血糖升高 。我们计算量的时候往往都是通过计算热量来获得,如果患者无法找到合适的量可以到医院寻求营养师的帮助,让营养师帮你量身制定一个糖尿病饮食方案 。
什么时候吃最好?
首先我们不建议餐前或者餐后马上食用,吃完水果后马上吃饭或者吃完饭马上吃水果肯定会导致血糖突然升高,这对于身体肯定是不利的 。一般我们建议空腹或者饥饿的时候、运动或体力劳动之后、距离吃饭2个小时以上(也就是两餐中间)的时候吃,这时候血糖都在一个比较低的水平,这些时候吃水果不会导致血糖出现大幅度的波动 。
糖尿病病人对水果的要求是:尽量不碰含糖量高的水果如桃子、梨子`柿子、葡萄、芒果、橙子、桔子等等 , 而香樵,西瓜等等也应尽量少吃,平时糖尿病患者可以吃些柚子和猕猴桃等水果 。糖尿病患者应养成良好的生活习惯,要管住嘴迈开腿 。使血糖保持相对稳定的状态 。
把握好量,什么都能吃[祈祷][祈祷][祈祷][祈祷]
我就是糖尿病患者 。刚查出来俩个月 。到目前为止 , 俩月了还没吃一口水果 。想吃?。】傻萌套牛÷窗桑∠却永孀涌?。听糖友们说梨的含糖量少点 。

文章插图
文章插图
4、糖尿病不能吃的水果 糖友不能吃的水果有哪些1桂圆
导致血糖迅速升高 。桂圆含糖量较高,食后消化吸收的速度快,可迅速导致血糖升高 , 不利于糖尿病患者控制病情 。
2大枣
可能损害糖尿病患者的消化功能 。虽然大枣含有丰富的营养物质,但是大枣的含糖量很高 , 尤其是晒干后的大枣(每100克鲜枣含糖20%以上,干枣达到60%-70%),食用后会快速升高血糖 。胃肠功能不好的糖尿病患者如果过量食用大枣 , 还会损害消化功能,造成肠胃的不适 。
3柿子
血糖控制欠佳者不宜食用 。柿子是含糖量较高的一种水果,食用后会迅速升高血糖,因此糖尿病患者食用柿子一定要注意不要过量,否则会加重胰岛细胞的负担 。柿子含有大量的柿胶,空腹食用柿胶会与胃部分泌的胃酸在胃内凝聚成硬块;当硬块越积越大时,可能导致无法排出,医学上称为“胃柿石病” , 因此,即使食用也不宜空腹吃 。
4葡萄
对糖尿病肾病患者有害 。葡萄的含糖量较高,且以葡萄糖为主,能很快的被人体吸收,迅速升高血糖,不利于血糖的控制 。葡萄干的果糖含量高达60%,比葡萄的含量更高,因此糖尿病患者忌食葡萄干 。葡萄含钾元素较丰富,特别不适合糖尿病肾病患者食用 。
文章插图
文章插图
5、糖尿病不可以吃什么水果?糖尿病不可以吃的水果有哪些?糖尿病患者要严格控制糖分的摄入,众所周知,水果含有丰富的维生素和营养成分,有些水果含糖少,糖尿病患者可以放心食用,有些水果对于糖尿病患者食用会造成很多威胁 。快来认识一下吧!
糖尿病不宜什么水果菠萝、芒果
都是常见的热带水果,生糖指数高,糖尿病患者不宜多吃 。二者又同属于致敏食物,过敏体质的人仅仅接触果皮,也有可能过敏 , 因此过敏体质者要慎食 。菠萝和芒果用盐水浸渍后食用,并不能减少过敏发生机会,只能改善口感 。
经验总结扩展阅读
- 煮熟的樱桃有什么功效,水果之王车厘子能煮着吃吗?
- 哪一种运动适合老年人锻炼,适合老年人的健身运动有什么
- 自然之宝木瓜酵素怎么样,水果酵素几天才能喝
- 茶跟咖啡哪一种更提神,茶和咖啡哪一个提神?
- 橙子的季节,橙子是什么季节的水果
- 被冻成冰糖葫芦的多肉,冰糖葫芦在冰箱冷冻最多能放几天 冰糖葫芦是什么水果做的
- 哪一种血型可以输给其他不同血型,四种血型中哪种可以互相输血???
- 纤美瘦胶囊多少钱一盒,纤美水果瘦多少价格 纤美水果瘦多少钱啊 有知道的吗
- 蜂胶软胶囊糖尿病人可以吃吗,请问?糖尿病人可以吃蜂胶吗?
- 有三种水果每次只能拿两种水果有几种拿法,有三种水果,每次只能拿2种,一共有多少种拿法
